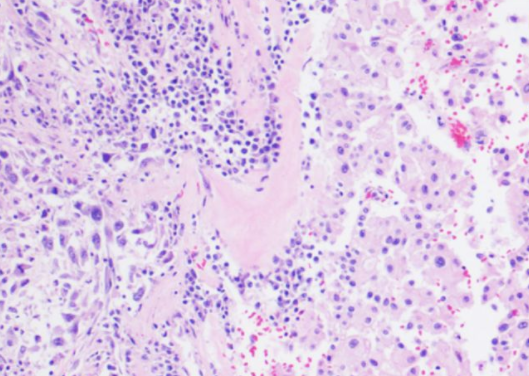
什么是嫌色细胞癌

最佳回答
本文由作者推荐
详细内容
- 01
肾嫌色细胞癌是一种非常见的肾细胞恶性肿瘤,但与普通的肾细胞恶性肿瘤相比,它的恶性程度相对较低,它的形态比较特殊,恶性程度不高,根据临床医学认识,它起源于肾集合管上皮,目前在治疗此类恶性肿瘤时,大多会进行根治性切除。
- 02
全肾脏切除后往往预后效果好,与同期其他类型的恶性肿瘤相比,它的5年生存期比例相对较大。

- 03
对于患者来说,做到早发现早治疗相当重要。它的早期症状相对较少,但是肿瘤增大后可以出现明显的血尿、持续性腰痛,同时多伴有腹部包块,以上症状也被临床医学上称之为肾癌的三联征,若出现以上症状要引起重视。

广告位
点击排行
- 2 排行
- 3 排行
- 4 排行
- 5 排行
- 6 排行
- 7 排行
- 8 排行
- 9 排行
- 10 排行
广告位





















